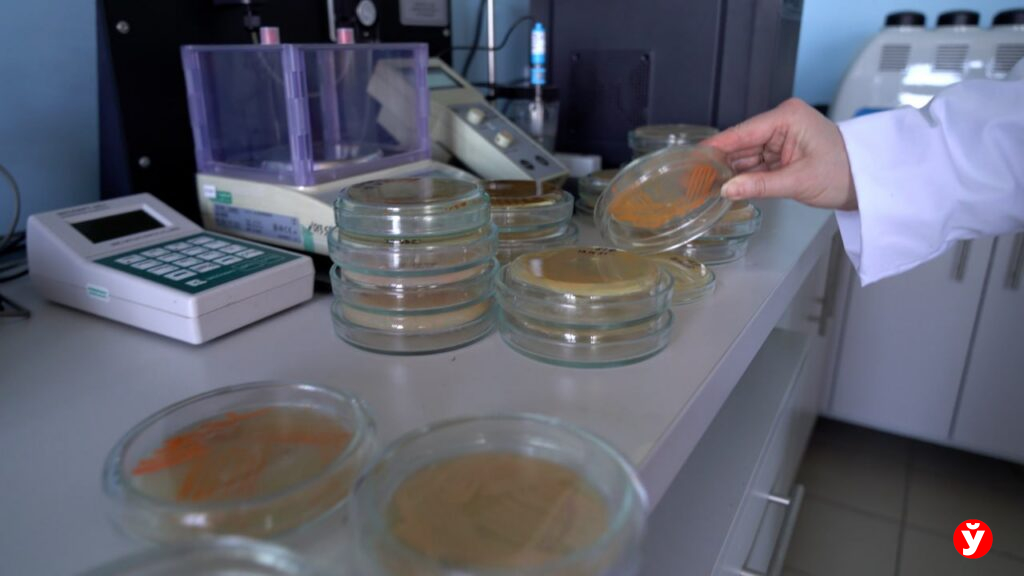
Они едят нефть: белорусские ученые заставили бактерии очищать почву от топлива

Больше никаких улиток! Способ, который уберет вредителей с участка

Нет ничего более разочаровывающего для садовода, чем увидеть утром результаты ночной работы прожорливых улиток на тщательно выращенной рассаде. Неделями вы заботились о своих нежных ростках, обеспечивали им оптимальные условия для роста, а проснувшись, обнаруживаете объеденные листья и характерные блестящие дорожки слизи – свидетельства ночных визитов этих моллюсков. Улитки, как известно, наиболее активны в ночное время, когда их практически невозможно обнаружить. Днем они прячутся в тенистых, влажных местах, под листьями или камнями, поэтому борьба с ними требует не только терпения, но и знания их повадок. Определить масштаб бедствия можно лишь утром, когда станет очевидно, насколько сильно пострадали ваши растения.
Но не стоит отчаиваться! Существует множество доступных и эффективных способов борьбы с этими вредителями, не прибегая к химическим препаратам, которые могут навредить окружающей среде и вашему здоровью. Один из самых простых и неожиданно действенных методов – использование обычной кофейной гущи. Кажется невероятным, но этот доступный продукт способен стать настоящим щитом для вашей рассады. Резкий аромат кофейной гущи и ее грубая текстура создают для улиток непреодолимый барьер. Даже тонкий слой, аккуратно рассыпанной вокруг растений, образует эффективную защиту. Для лучшего результата гущу следует распределить в виде плотного кольца, создавая непрерывную линию вокруг каждого растения или грядки.

Однако, важно помнить, что эффективность этого барьера зависит от его целостности. После дождя или сильного полива кофейная гуща может смыться, создавая бреши в защите, через которые просочится ненасытная армия улиток. Поэтому необходимо регулярно обновлять защитное кольцо, поддерживая его непрерывность и плотность. Малейший разрыв станет для улиток приглашением к пиру, сведя на нет все ваши усилия. Помимо отпугивающего эффекта, кофейная гуща приносит дополнительную пользу. Кофеин и кислоты, содержащиеся в ней, постепенно улучшают качество почвы, делая ее более рыхлой и насыщая азотом, что положительно сказывается на росте растений. Это своего рода «два в одном»: защита от вредителей и удобрение почвы.

Если же вы не являетесь поклонником кофе, не стоит расстраиваться. В арсенале садовода есть и другие натуральные средства борьбы с улитками. Например, хвойные иголки, создающие колючий барьер, неприятный для моллюсков. Улитки избегают контакта с острыми краями иголок, предпочитая обходить подобные препятствия стороной. Еще один доступный вариант – сухая горчица. Ее порошок, рассыпанный вдоль грядок, вызывает раздражение у улиток, заставляя их искать другие пути. Эффективность горчицы усиливается после полива, когда ее аромат распространяется в почве, делая ее еще менее привлекательной для улиток.

Древесная зола также проявляет себя как эффективный отпугивающий агент. Щелочная среда золы создает дискомфорт для улиток, а мелкие частицы золы, прилипающие к их телу, замедляют их передвижение. Для достижения максимального эффекта рекомендуется комбинировать различные методы защиты. Например, чередование полос кофейной гущи и древесной золы обеспечит не только надежную защиту растений, но и обогатит почву, создавая благоприятные условия для их роста и развития. Помните, что регулярный осмотр растений, своевременное удаление сорняков и создание благоприятных условий для полезных насекомых, естественных врагов улиток, также являются важными составляющими успешной борьбы с этими вредителями. Комплексный подход, сочетающий в себе различные методы, гарантирует наилучший результат и сохранит ваш урожай от нашествия прожорливых улиток.
Рекомендуем